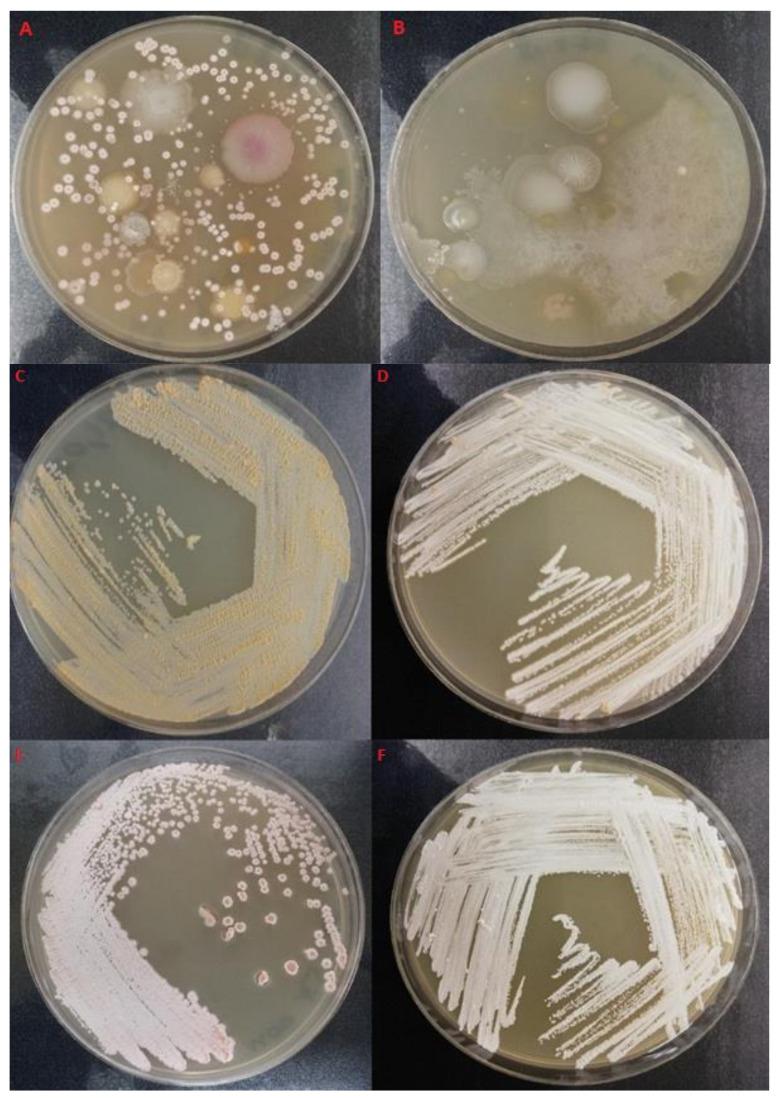
https://cdn.ncbi.nlm.nih.gov/pmc/blobs/49f4/8151412/ceaae2e54365/pathogens-10-00579-g001.jpg

与沿海海水泡沫相关的诺卡氏菌的分离与鉴定
Isolation and Characterization of Nocardiae Associated with Foaming Coastal Marine Waters.
作者信息
Wright Luke, Katouli Mohammad, Kurtböke D İpek
机构信息
Genecology Research Centre, School of Science, Technology and Engineering, University of the Sunshine Coast, Maroochydore, QLD 4558, Australia.
出版信息
Pathogens. 2021 May 10;10(5):579. doi: 10.3390/pathogens10050579.
Nocardiosis is an infectious disease caused by species that occurs worldwide, albeit more prevalently in tropical/subtropical regions. It can appear as either acute, subacute or as a chronic infection mostly with those with a compromised/weakened immune system. Inhalation of spores and or mycelium fragments is the main transmission route for developing pulmonary nocardiosis. In contrast, cutaneous nocardiosis usually occurs via direct contact. In the subtropical region of the Sunshine Coast in Australia foaming events with thick and persistent and orange-brown color foam have been observed during summer seasons in the near shore marine environments. This study reports the existence of nocardiae in these near shore marine environments by the use of a novel isolation method which used the gas requirements of nocardiae as a selective battery. A total of 32 nocardiae were isolated with the use of this novel method and subsequently conducted molecular identification methods confirmed that the isolates belonged to the genus . Twenty-one isolates out of the 32 were closely related to strains MGA115 and one was related to CBU 09/875, in addition when compared with human pathogenic nocardiae twenty of the isolates were found to be related to strain JCM 6044. Isolates displayed varied resistance against some of the antibiotics tested when interpretation threshold recommended the Comite de L'Antibiogramme de la Societe Francaise de Microbiologie were used. The highest level of resistance against cefotaxime ( = 27) and ceftriaxone ( = 24). Some of the isolates ( = 6) that displayed resistance to selected antibiotics also possessed potential human pathogenic characteristics such as adherence and translocation through human long epithelial cells as well as displaying phage resistance ( = 26). They might thus present a potential public health risk if frequently encountered through exposure to aerosols generated by the foam as well as direct contact through a wound. Preventative measures to control the growth of nocardiae in such environments such as the control of pollutants, might prevent potential infections that might be caused by these bacteria in humans as well as in marine animals.
诺卡菌病是一种由诺卡菌属物种引起的传染病,在全球范围内均有发生,不过在热带/亚热带地区更为普遍。它可以表现为急性、亚急性或慢性感染,主要发生在免疫系统受损/虚弱的人群中。吸入孢子和/或菌丝体片段是发生肺诺卡菌病的主要传播途径。相比之下,皮肤诺卡菌病通常通过直接接触发生。在澳大利亚阳光海岸的亚热带地区,在夏季的近岸海洋环境中观察到了产生浓稠、持久且呈橙棕色泡沫的起泡事件。本研究通过使用一种新颖的分离方法报告了这些近岸海洋环境中诺卡菌的存在,该方法利用诺卡菌的气体需求作为选择筛选条件。使用这种新颖方法共分离出32株诺卡菌,随后进行的分子鉴定方法证实这些分离株属于诺卡菌属。32株分离株中有21株与菌株MGA115密切相关,1株与CBU 09/875相关,此外,与人类致病性诺卡菌相比,发现其中20株分离株与菌株JCM 6044相关。当使用法国微生物学会抗菌谱委员会推荐的解释阈值时,分离株对某些测试抗生素表现出不同程度的耐药性。对头孢噻肟(n = 27)和头孢曲松(n = 24)的耐药水平最高。一些对选定抗生素表现出耐药性的分离株(n = 6)还具有潜在的人类致病特征,如通过人肠上皮细胞的黏附和易位以及表现出噬菌体抗性(n = 26)。因此,如果通过接触泡沫产生的气溶胶以及通过伤口直接接触而频繁遇到它们,可能会带来潜在的公共卫生风险。控制此类环境中诺卡菌生长的预防措施,如控制污染物,可能会预防这些细菌可能在人类以及海洋动物中引起的潜在感染。